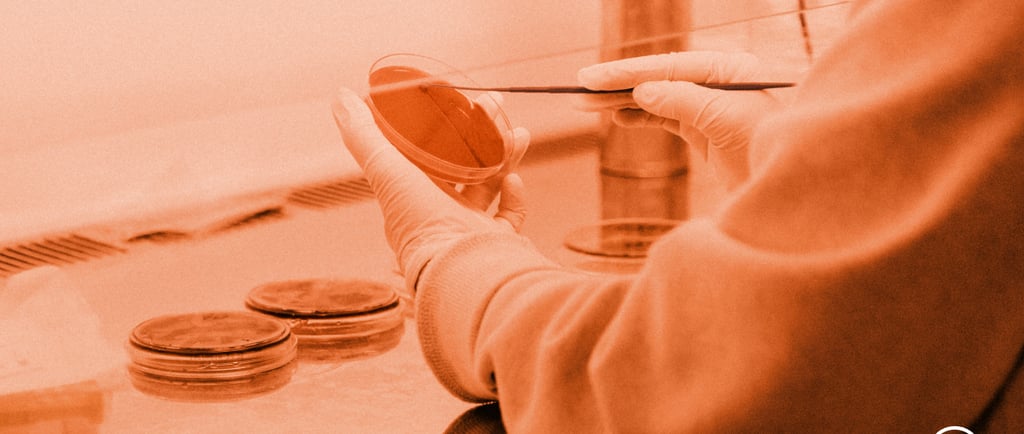
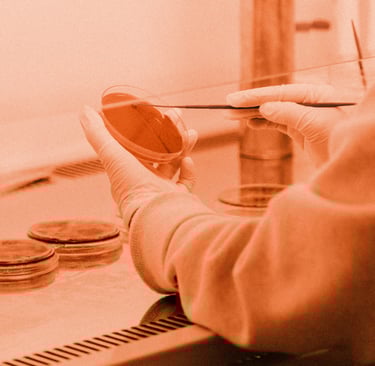

Intelligence artificielle et cancer : la révolution silencieuse de l’oncologie
Des logiciels capables de repérer des tumeurs invisibles à l’œil humain, des algorithmes qui anticipent la réponse aux traitements : l’intelligence artificielle s’impose désormais comme un outil central de la lutte contre le cancer. En France comme ailleurs, les progrès sont fulgurants et bouleversent déjà la pratique médicale.
ACTUALITÉS

Des images qui parlent plus que des mots
Dans les hôpitaux et les centres de recherche, l’intelligence artificielle (IA) n’est plus un concept, mais une présence quotidienne. Radiologues et pathologistes s’appuient sur des algorithmes capables d’analyser des milliers d’images en quelques secondes, de repérer des anomalies infimes, d’alerter avant même qu’un œil humain ne s’interroge.
Dans le dépistage du cancer du sein, certaines IA atteignent déjà une précision supérieure à celle des praticiens expérimentés. En France, plusieurs hôpitaux testent des outils comme MammoDiag©, qui assiste les radiologues dans la lecture des mammographies, réduisant les faux positifs et les délais de diagnostic.
« L’IA ne remplace pas le regard du médecin, elle l’affine », explique la professeure Sarah Watson, chercheuse à l’Institut Curie, où une équipe développe un outil d’intelligence artificielle pour identifier les cancers d’origine inconnue, ces tumeurs dont on ne retrouve pas le foyer primaire.
Du diagnostic à la stratégie thérapeutique
L’IA ne se contente plus d’identifier la maladie : elle apprend à la comprendre.
En croisant des données d’imagerie, de biologie et de génétique, les modèles prédictifs dessinent aujourd’hui des profils de patients et anticipent leurs réponses aux traitements. Cette approche, baptisée oncologie de précision, permet de choisir la combinaison thérapeutique la plus efficace et la moins toxique.
Des projets européens, comme ASCAPE, vont encore plus loin : ils visent à ajuster les protocoles au fil du temps, en analysant l’évolution tumorale et les effets secondaires en continu. Une forme de médecine dynamique, où chaque patient devient une source de données permettant de nourrir les modèles d’apprentissage.
Une révolution française discrète mais réelle
Longtemps en retrait face aux géants américains, la France s’impose peu à peu comme un acteur crédible de cette révolution. La start-up Owkin, fondée par le médecin français Thomas Clozel, a développé une technologie d’apprentissage fédéré : elle entraîne des modèles d’IA à partir des données de multiples hôpitaux sans jamais transférer les dossiers des patients, garantissant ainsi la confidentialité médicale.
Dans les centres de cancérologie du réseau Unicancer, la plateforme ConSoRe (Continuum Soins Recherche) permet d’explorer des millions de comptes rendus médicaux et d’images anonymisées. Ces données alimentent les modèles d’IA utilisés pour détecter des schémas invisibles à l’œil humain et accélérer la recherche clinique.
« Nous sommes entrés dans une ère où chaque décision médicale repose sur des milliards de points de données », résume un chercheur du Centre Léon Bérard à Lyon. « Notre rôle n’est plus seulement de diagnostiquer, mais de comprendre ce que la machine nous apprend. »
Les promesses d’une médecine augmentée
Les bénéfices sont déjà mesurables : diagnostic plus rapide, traitements mieux ciblés, rechutes détectées précocement.
Aux États-Unis, la FDA a validé plusieurs dispositifs d’IA pour la détection du cancer de la prostate et du poumon. En Europe, des essais cliniques associent désormais ces outils à la radiothérapie pour ajuster les doses en temps réel, selon la réaction de la tumeur.
L’IA permet aussi d’identifier de nouveaux marqueurs biologiques, ouvrant la voie à des thérapies personnalisées. Des équipes d’Harvard ont récemment montré qu’un algorithme pouvait prédire, à partir d’une simple lame de biopsie, les altérations génétiques d’une tumeur — un pas vers la prédiction moléculaire automatisée.
Une transformation éthique et culturelle
Mais au-delà de la performance technique, c’est une véritable mutation de la culture médicale qui s’opère.
Les médecins doivent apprendre à dialoguer avec des outils dont ils ne maîtrisent pas toujours le fonctionnement interne. Les patients, eux, devront accepter que des algorithmes participent au diagnostic et à la décision thérapeutique.
Les institutions travaillent déjà à définir le cadre de cette collaboration : certification des logiciels, responsabilité en cas d’erreur, transparence des données.
« Ce qui se joue, ce n’est pas la victoire de la machine sur le médecin, mais leur alliance », souligne le professeur Jean-Yves Blay, directeur général d’Unicancer. « L’IA ne remplace pas la décision médicale ; elle la rend plus juste. »
Vers une nouvelle ère de la cancérologie
L’intelligence artificielle marque un tournant : le cancer n’est plus seulement une maladie à combattre, mais un système à modéliser.
En cartographiant les mécanismes intimes des tumeurs, en intégrant des volumes de données inaccessibles à l’humain, l’IA redéfinit les contours de la médecine.
Ce n’est plus le corps qui parle, mais le langage des données — et c’est dans cette conversation entre l’humain et la machine que s’invente la cancérologie du XXIᵉ siècle.
